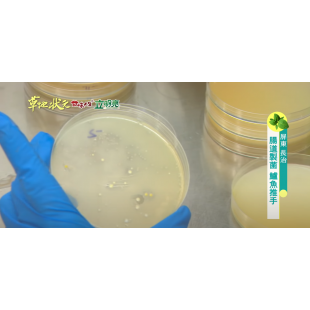
Image 1.png

All MEDIA
-

【行政院農委會】農委會進軍馬來西亞 共創農業綠經濟奇蹟
發布日期:107-10-25
發布機關:農委會(國際處)
行政院農業委員會組團參加本(25)日起至27日止在馬來西亞吉隆坡國際會議中心(KLCC)舉辦的「馬來西亞臺灣形象展」(TAIWAN EXPO 2018 in Malaysia),向馬國推介臺灣優質農產加工食品、農業機械、自動化設備,以及生物農藥與微生物肥料等產品,拓展我國農業產品多元銷售市場,開創新南向商機。
農委會表示,馬來西亞人口約3,200萬人,華人占4分之一,經濟年成長率達5.4%,人均購買力為東協第三高(27,300美元),農業占GDP比重約9.1%。馬國政府於2010年推動「經濟轉型計畫」(Economic Transformation Program, ETP),並在2011年提出十年國家農業政策,以提高農業GDP、增加糧食產量、保障糧食安全及提高農產品附加價值為主要目標,是我國推動農業新南向的重要目標市場。
這次由農委會組團參展的6家臺灣優質農企業,包括以臺灣在地素材製作高品質即沖乾燥食品,且擁有HALAL及多項國際食品安全認證的京工興業有限公司;通過歐盟認證,生產自然無食品添加物素香鬆及魚鬆的味一食品有限公司;提供先進農業溫室微氣候監控設備,以及可調整太陽光譜光質披覆材料的磐磬實業有限公司;生產動物疫苗及農藥殘留與食品安全試劑,以及提供檢測技術、產品開發及銷售服務等全方位服務的台灣尖端先進生技醫藥(股)有限公司;生產生物性肥料及永續農用資材的台農生物科技(股)有限公司;還有生產冷凍鱸魚片與魚丸,以及提供「階段式循環水養殖系統模組」的峰漁股份有限公司等。未來幾天這些業者將展示符合馬國需求的臺灣優質農業產品,希望能掌握馬來西亞龐大市場商機。
農委會指出,該會為拓展馬來西亞市場,除結合相關產業公會、協會、縣市政府及農民團體參加馬來西亞清真展與形象展外,並在馬國超市系統舉辦臺灣蔬果節,同時也針對馬國清真市場進行商機研究及舉辦業者媒合活動,今(107)年1月至9月我國農產品外銷馬國金額達7,500萬美元,較去年同期成長12%,顯現推動農業新南向各項工作已有實質成效。【行政院農委會】農委會進軍馬來西亞 共創農業綠經濟奇蹟more -

【台灣好新聞】全球生技研發產製需求增溫 經部辦臺日交流促跨國合作共創商機
經濟部中小企業處今(30)日邀請來自日本沖繩、福岡的8家優質生技業者以及台灣19家優質企業,共同參與「躍升生技新次元–2018中小企業商機創造展示交流會(臺南場) 」,現場展出臺日最新權威技術與先進產品,吸引不少跨領域的企業代表到場交流爭取合作機會。
全球人口高齡化、生活品質高質化,以及全球農林漁牧業因應氣候變遷而必須調整養殖與栽種模式,都是推動各國生技、醫藥領域持續開創更多可能的直接原因,也因此帶動相關產業大幅邁進、產值持續飛速飆高。我國已將生技醫療產業列為國家重點發展「5+2創新產業」政策中非常重要的一環,而臺灣中小企業扎實的產製技術實力,以及豐沛的設計與行銷創意,都與專長於核心技術研發的日本企業有著高度的互補性,若能凝聚彼此能量,共創市場商機的成功率可說是非常高!
與臺灣維持緊密商務關係的日本,一直是生技製藥領先國家之一,於全球產業脈動具有舉足輕重的地位。本次來臺參展的8家企業涵蓋醫材、藥妝、資訊系統等領域。業者表示,Protein Tomography的獨家斷層攝影技術,可簡化並快速捕捉蛋白質與複合物分子結構變化,並以獨家軟體建構個別分子的三維結構;Jectas Innovators專精於豬隻水腫病的疫苗,在豬隻養殖業極為興盛的亞洲地區,特別是臺灣、日本、中國大陸,皆具有非常大的市場潛力;晶圓加工設備起家的株式會社FAE電子,近年跨足醫材產業,發表極細注射針頭、血管支架等體內極細導管的加工技術,結合獨創的極細管用捲線張力控制器,可優化葉克膜濾心與洗腎透析等設備功能。
這次活動涵蓋生技、美妝、保健、醫材等四大面向共19家企業參展。臺南的花卉培育技術享譽國際,蘭卉以蝴蝶蘭,而穎麗生技以黃花石斛為基底,提供頂級美妝保養品,解決女性在意的肌膚問題。禎和先進、麗豐實業、豐華生技、峰漁等公司,都鎖定微生物發酵與菌種培育技術,除了各家獨門配方外,也可客製化後廣泛運用於醫療保健、動物養殖與植栽用益生菌,甚至水產育種等領域。喬本生醫致力將中草藥現代化,利用超臨界二氧化碳萃取技術大幅提高萃取率;慕康生技、神農資訊在發展醫療輔具上多有斬獲,對改善病患生活、提升醫療品質的貢獻,也分別獲得磐石獎、多國智財權的肯定。
經濟部中小企業處每年依區域特性建立商機媒合管道,也藉由工研院與日本關連機構的友好關係,協助台日中小企業尋得研發、製造、行銷、資金等方面的合作夥伴。若有意尋求技術、行銷、資金合作的企業,可上「中小企業商機媒合整合服務網」( www.technomart.org.tw)查詢。
【台灣好新聞】全球生技研發產製需求增溫 經部辦臺日交流促跨國合作共創商機more -

【天下雜誌】習農再從農,農業大學養專才
行政院主計總處統計,2016年屏東縣農產總值高達702億,然而這全台第二大農業縣,也面臨著農村高齡化困境,為了吸引更多新血從農,傳統農業的轉型刻不容緩。然而轉型要成功,就必須仰賴知識技術和思維改變,「農業大學也就因此應運而生,肩負起屏東農業走向世界的關鍵角色」,縣長潘孟安點出關鍵。
圖片來源:屏東縣政府
文 屏東縣政府
整合傳播部企劃製作
2018-08-20
學知識、交朋友,農業大學營造共好圈
屏東一早的豔陽就把皮膚曬到發燙,不過鱸魚養殖池畔邊,有張年輕面孔卻不怕太陽曬,她不時來回巡邏、觀察水質,任何小細節都不馬虎。33歲的王靜儀是農業大學第一屆專修班學生,她完全沒有水產養殖背景,卻對水產養殖有濃厚興趣。她和丈夫劉建伸堅信,水產養殖不一定要靠抗生素、藥物,因此夫妻倆研究如何用益生菌提升魚類免疫力,並希望透過品牌行銷,將環境永續又健康自然的養殖方式推廣。
於是夫妻倆分工,先生負責打造友善環境的鱸魚種苗繁殖基地,王靜儀則到農業大學進修,學習水產品後端加工、創業經營、行銷相關課程,也因此接觸到網路募資平台,並成功打造自有品牌「峰漁佳食」,他們生產的鱸魚排還榮獲農委會評選「2017年銀髮友善食品」,鱸魚種苗更取得產銷履歷,順利進軍市場。
王靜儀回想,自己和先生都是農業新手,對加工、推廣、通路都不懂,進入農業大學練功,學到如何精確計算成本、制定合理價格等瑣碎卻又重要的技術環節。不過更重要的收獲還有人脈資源,王靜儀表示,由於同學中有水產界前輩,願意傳授寶貴經驗,省下許多摸索時間,其他領域的農友也都會定期聚會,互相分享事業經營心得,幫助相當大。
學會務實,以企業家精神從農
台灣地小人稠,農業必須朝專業、精緻、高附加價值發展;比的不是產量,而是產值,要達到目的,就必須貼近市場趨勢。屏東縣政府農業處長黃國榮指出,台灣氣候多變,近年來也面臨極端氣候威脅,因此有保護能力、能防範病蟲害的農業設施必須普及化,像是屏東縣溫室產出的聖女小番茄和香瓜,頗受市場歡迎,也能拉高單價。此外,農業4.0時代,傳統施作方式已不足以應付多變環境,善用科技,像是田間管理APP,能搭配感測儀器,隨時監控量測田間溫度、濕度、土壤酸鹼值,讓農夫能精準控制環境變因,掌握作物生長狀況。
對此,屏東縣政府2018年已跟資策會提出智慧城鄉專案申請,期許屏東農業逐步轉型為「智慧農業」,除了屏東農改場實驗田正進行相關實驗外,科技趨勢、技術應用與知識推廣,也納入農業大學課程,要讓農友們與時俱進。
黃國榮進一步指出,農民培養企業家思維同樣重要,因為以「商品」角度看待自己的農作,才能從消費端需求思考,需生產什麼樣的產品迎合市場?現代農民不僅要走向專業化、智慧化,更得懂得成本管控、經營管理、行銷推廣,而這也是農業大學創立的初衷之一。
屏東縣多年前開始便鼓勵青農返鄉,農業大學的成立,不僅是返鄉青農能獲得資源,在地青年和傳統農友也有機會接受專業農事教育,其中也不乏原住民及新住民加入,目前農產品類型包含各式蔬果、漁產、牧草、雜糧、辛香料等,可望為屏東農業注入更多活力。
農業界的EMBA:匯聚人才、經驗和資源
從農最大的挑戰向來是技術與財源,農業大學、農改場也提供習農平台,每年開設120小時的「入門班」、「基礎班」及「專修班」各60名,學員可依據自身需求和相關經驗選修。「入門班」著重於農業生產基礎技術,「基礎班」則以作物栽培技術與實務、農作物採收及加工處理、土壤肥料病蟲害管理與診斷技術、農藥概論及實務等課程為主;「專修班」學的是農產品加工行銷、農業成本分析與利潤、銀行貸款、投資專案評估等。
農業大學還邀請知名農企負責人擔任業師,分享企業經營、品牌、通路等經驗,例如經營有機休閒農場有成的許哲榮、鳳梨外銷日本並註冊「銀獅」品牌的洪銘聰等都是講師。
屏東農業大學開辦4年來,累積迄今已有5百多位學員,平均年齡40歲,歷屆學員中不乏優秀青農,包括神農獎得主潘志民,60年老店「鳳梨世家」第三代陳詩佩、以有機小黃瓜闖出名號的「茂和農園」羅秉諺、引進台灣第一座全自動化管理科技雞舍的「搖滾雞農」陳健福等。透過農業大學的平台,把人才匯聚一堂,經驗與創意互相激盪,也難怪農業大學被喻為「農業界的EMBA」,每屆吸引四、五百人報名搶破頭。
至於財務的挑戰,縣府未來將針對完成課業的學員,提供300萬以下微型創業貸款,也會與民間合資成立「台灣屏東農業國際運銷股份有限公司」,協助農民把產品賣出去,甚至賣到海外市場,達到產銷一致、帶動其他產業鏈,大大活絡屏東經濟發展。
台灣味,用農業征服全世界
誰說農業一定得看天吃飯?時至今日,農業已經搖身一變,懂得高度應用智慧科技,並善於品牌行銷,成為高附加價值的產業。「農夫」也從過去一人單打獨鬥,轉變為以「農企業」為主體,打群架才能搶到商機。屏東是農業大縣,有人才、有技術、有天時地利,絕對有條件在綠金浪潮上乘風破浪,從台灣的最南端走向全世界。
【天下雜誌】習農再從農,農業大學養專才more -

【行政院農委會】運用在地優質食材加工 銀髮友善食品為長者飲食加分
「2018年銀髮友善食品獲選產品頒獎典禮」於本(107)年6月30日在臺北國際食品展臺灣館溫馨登場,農委會李退之副主任委員特別蒞臨現場頒獎,並致詞時表示,我國已邁入高齡社會,無論是健康或是需要被照顧的老人,都需要營養適口及方便料理的產品來維持或促進其身體機能;農委會與食品工業發展研究所偕同國內食品業者,運用創新加工技術開發具營養機能、風味口感及料理便利性之銀髮友善食品,相當歡迎各界共同體驗長者飲食新風貌。
農委會進一步說明,滿足高齡長者飲食生活之新產品及新服務為重要商機,尤其臺灣生產多樣化且新鮮優質的農漁畜產品,透過食品科技加值,不僅擴大在地食材應用,更為長者增加飲食多元性及選擇性,協助高齡社會健康發展。隨著各界對銀髮友善食品認知及需求逐漸升溫,農委會自2016年起舉辦「銀髮友善食品」評選及推廣活動,獲得各界關注及熱烈參與,前兩年已評選出26項銀髮友善產品。而本年度計有31家業者、87項產品參選,經20餘位各領域專家就產品之生產品質管理、營養機能、質地特色、包裝份量及備餐等面向評選,最後有27項產品脫穎而出,包括7項整體表現優異之金饌獎產品及3項具食材獨特性與應用多元性之特別獎產品(名單如附件),後續也將持續和相關通路業者合作,透過媒合商品上架、設置網路平臺專區等方式與消費者互動,讓各界更重視高齡長者友善飲食。
農委會表示,奔波忙碌的生活已讓許多人忽略家中長者的飲食需求,何不讓在地嚴選、品質安全、烹飪便利及營養適口之「銀髮友善食品」傳達您對家中長者之關懷心意,讓飲食幸福持續維繫「家」的情感。更多有關銀髮友善食品之相關資訊,可上銀髮友善食品網頁(https://eatender.firdi.org.tw/)查詢。
2018年銀髮友善食品獲選產品名單
廠商名稱
產品名稱
備註
天和鮮物股份有限公司
澎湖箱網分切魚片快速料理組(青斑、鮸魚、赤鰭笛鯛)
金饌獎
天和鮮物股份有限公司
澎湖箱網分切魚片快速料理組(龍虎斑、嘉鱲、銀紋笛鯛【紅槽】)
金饌獎
光泉牧場股份有限公司
頂級希臘式優酪
金饌獎
安永生活事業股份有限公司
龍膽石斑魚排
金饌獎
佳辰實業股份有限公司
蒲燒台灣鯛魚腹
金饌獎
峰漁股份有限公司
菌沛無油鱸魚丸
金饌獎
駱駝鈴生機股份有限公司
Cepis有機營養黑寶黑米芝麻飲
金饌獎
佳辰實業股份有限公司
東港櫻花蝦
特別獎
青葉食品工業股份有限公司
青葉有機綜合菇
特別獎
得意中華食品有限公司
秋刀魚
特別獎
允偉興業股份有限公司
活力生態鯛
允偉興業股份有限公司
耐心花鱸-去刺七星鱸魚切片
天和鮮物股份有限公司
海藻豬獅子頭
玉美研究股份有限公司
有機貝比生菜
光泉牧場股份有限公司
紫米燕麥糙米漿
佳辰實業股份有限公司
台灣鯛魚切片
佳辰實業股份有限公司
台灣鯛魚片
味全食品工業股份有限公司
林鳳營簡單點優酪乳 無加糖
青葉食品工業股份有限公司
青葉嚕肉飯料
南僑集團華強實業股份有限公司
美味熟飯
得意中華食品有限公司
鯖魚一夜干
統一企業股份有限公司
牛奶蒸果子
統一企業股份有限公司
及第小籠湯包
黑橋牌企業股份有限公司
香腸蘿蔔糕
福記冷凍食品股份有限公司
台灣紅豆湯
福記冷凍食品股份有限公司
芋頭甜湯
歐典生物科技股份有限公司
歐典生機養生黑木耳
註:依獎項及公司名稱筆畫順序排序。
資料來源:財團法人食品工業發展研究所。
【行政院農委會】運用在地優質食材加工 銀髮友善食品為長者飲食加分more -

【新春自由行】屏東縣-潘孟安縣長
邀請潘孟安縣長推薦屏東縣各種好吃好玩資訊,並以屏東縣好物、秘境景點、IG夯點、樂齡生活為為主題進行介紹。
同時亦不可錯過2018屏東熱帶博覽會及四重溪溫泉季,透過活動之豐富及特色介紹,吸引觀眾前往屏東旅遊。
民視Youtube新聞節目: https://www.youtube.com/FTVNP
民視Youtube新聞: https://www.youtube.com/FTVCP
民視Youtube綜藝: https://www.youtube.com/FTVPLAY
民視Youtube戲劇: https://www.youtube.com/FTVDRAMA【新春自由行】屏東縣-潘孟安縣長more -

草地狀元-腸道製菌鱸魚推手(20181224播出)
王靜儀夫妻倆人一起投入鱸魚和吳郭魚魚苗養殖,提供漁民養成成魚,利用循環水並自製活菌營養劑,提供魚苗完整的營養來源,減少使用抗生素,朝向完全無毒養殖。
而在養殖的過程發現市售益生菌並非是萬用,而苦心研究採集魚體內益生菌做為培養專屬的益生菌,更適合當池的池水使用
免費訂閱草地狀元,讓黃西田帶你看見台灣職人的精神↓↓
https://www.youtube.com/user/set29itake
更多最新消息與活動資訊,請前往草地狀元FB粉絲頁↓↓ .
https://www.facebook.com/set.careermaster/
草地狀元-腸道製菌鱸魚推手(20181224播出)more -

【食力】老齡化的台灣社會可以「吃」什麼?這16項產品努力獲肯定
撰文=張越評
據聯合國世界衛生組織定義,65歲以上老年人占總人口比例達14%時即稱「高齡社會」。據內政部統計,2017年時台灣65歲以上長者已高達13.6%,即將正式邁入老齡社會結構,產業如何因應的問題迫在眉梢。行政院農委會主辦之「銀髮友善食品」評選優良產品邁入第二屆,在食品性質開發中,鼓勵更大幅度針對銀髮族的需求努力。自食材來源、營養、質地、風味、方便性等高齡友善與否的評比中,本屆10家業者產品脫穎而出。
評審主要委員台灣大學名譽教授孫璐西表示,本屆20家廠商提出44項產品,共27項入圍,評委再經4項環節進行第二階段評分,如「原料與加工製程等生產品質(20%)、營養均衡度(35%)、質地是否銀髮友善(20%)、份量與包裝等便利度開發(25%)」,評委藉由當場品嚐,看是否咀嚼後是否產生餘渣、復熱是否方便、營養濃度(低鈉高纖高鈣高蛋白)足夠的情形下是否仍然美味,並以在地食材為主等等。
最終評選結果,獲肯定名單包含「天和鮮物、峰漁、瀚頂生技之魚肉及魚湯產品;大成長城、新東陽雞肉鬆產品、金口香麻油雞粥、南僑熟飯、統一極制低溫殺菌鮮乳、漢佑食品虱目魚精、臺鹽的鹽麴」等16項。為符合易咀嚼、營養密度高且好吸收等特點,魚相關產品就占了一半,孫璐西對此也鼓勵業者,希望下一屆能往「素食」銀髮友善方向一同努力。
除風味、營養、食材來源之外,「咀嚼容易度」如何區分,以供銀髮族消費選擇時更能依據自身需要?畢竟何謂軟、何謂硬?並不是一張嘴巴就能決定,客觀的評斷標準如何訂定?較早邁入高齡社會的日本在這領域已發展有時,日本介護食品協議會2012年起,便開始藉實際品評與質構儀分析方式分類各食材質地,並在2016年由日本農林水產省統一咀嚼容易度的分級標準,業者可依據標準開發真正對長者友善的食品,消費者也能依據分級標章做採買。
食品工業發展研究所(以下簡稱食品所)扮演起這之中的橋樑,開始針對台灣常用食材一一分析其咀嚼難易度,建立出專屬台灣長輩的資料庫,業者開發產品時便可有所依循。據食品所所長廖啟成指出,過去專家分析,社會結構中老人超過14%時,高齡相關產業將逐漸浮現,農委會於2015年進入預備動作,從「科技型計畫(質地分析跟國際接軌)、台灣高齡者實際需求市場分析、舉辦推廣活動、建構網路交換資訊平台」四大方向持續邁進。
高齡介護食品的需求越來越不容忽視,然而一般大眾可能仍未感受到市場波動,雖然在技術上,介護食品的開發門檻並不難跨越,但在單價上恐怕得受市場的一番考驗,未來是否有業者願意開出第一槍大動作開拓高齡市場,待各界的共同關注和鼓勵。
行政院農委會「2017年銀髮友善食品」評選委員組成
大潤發流通事業股份有限公司
中華民國營養師公會全國聯合會
全家便利商店股份有限公司
食品工業發展研究所
益富營養中心
惠璿諮詢中心
臺中教育大學美術系
台北醫學大學口腔醫學院口腔衛生學系
台灣大學食品科技研究所
台灣大學醫學院附設醫院新竹分院復健科
台灣咀嚼吞嚥障礙醫學學會
台灣保健食品產業發展協會
台灣國際生命科學會
台灣優良食品發展協會
台灣優良農產品發展協會
樂齡生活事業股份有限公司
雙連安養中心
行政院農委會「2017年銀髮友善食品」獲選產品名單
天和鮮物海鱸魚魚排粥
天和鮮物黃金鯧魚排米粉
南僑集團華強實業膳纖熟飯健康雙麥飯
峰漁菌沛尖吻鱸魚排
大成長城鮮純雞肉鬆
新東陽純雞肉鬆
天和鮮物龍虎斑魚湯
統一企業瑞穗極制低溫殺菌鮮乳
瀚頂生物科技淳鮮-海牡丹鮮活飲
今口香調理食品紅蔾燕麥麻油雞粥
天和鮮物青斑高麗菜粥
瀚頂生物科技淳鮮-龍虎斑無骨法式魚排
瀚頂生物科技淳鮮-頂級蒲燒鰻魚
瀚頂生物科技淳鮮-海鱸厚切魚片
漢佑食品鱻魚露(虱目魚精)
台鹽實業鮮選我-塩麴
【食力】老齡化的台灣社會可以「吃」什麼?這16項產品努力獲肯定more -

【自由時報】屏東十大伴手禮暨好店出爐 今天頒獎
屏東十大伴手禮及好店今天頒獎。(記者羅欣貞攝)
2017/08/04 12:45
〔記者羅欣貞/屏東報導〕2017年屏東伴手禮暨好店徵選今天(4日)在青創聚落舉辦頒獎典禮,屏東縣長潘孟安與30間得獎的店家一同上台走秀展示入選產品,分享喜悅。潘孟安表示,伴手禮徵選活動邁入第4屆,商品與店家豐富而多元,更可喜的是,除傳統老店外,還有年輕人展現創意,令人耳目一新,歡迎大家踴躍選購支持。
今年屏東伴手禮暨好店徵選共有來自屏東各地的109間店家、147件產品報名參賽,戰況激烈,縣府除邀請產業專家評審外,並展開為期1個月的網路票選活動,有效投票數達43萬票,是有史以來最踴躍的一次。最後評選出食品組、非食品組、好店組商家共30名,成為屏東的好食、好物、好店的代言人。
觀光傳播處指出,這次伴手禮入選者涵括農產及族群文化,像食品組有不少產品都是選用有機、無毒原料製做,還有百大青農養殖道地的屏東鱻味,迎合現代人健康養生風潮,讓消費者食得安心;原鄉的琉璃珠、客家染布、石硯等,也經由巧思變化成優雅飾品。
得獎名單,食品組:六堆釀興業(豆油伯)-純釀無添加雙美好食味、多麥綠烘焙美食-黃金沙其瑪、佳鮇鮮生物科技-88津烤蝦、味益食品-東港fun輕鬆禮盒(海苔芝麻鮪魚鬆)、屏榮實業-屏榮蒲燒鰻魚禮盒、峰漁公司-菌沛好漁禮盒組、萃檸檬商號-檸檬茶佐原片、臺灣菸酒屏東酒廠-台酒紅麴豬腳、臻藏-鮮奶酪鮮而美食品工業-鮮而美水果乾禮盒。
非食品組:七星檀香-星洲陳盤香、大花農場-玫瑰精露、本革工坊-包粽零錢包、玉印霞飛手作坊-昌黎硯小吊飾、羽沛生物科技-羽沛沐香-諾麗果系列植萃皂禮盒、幸福手作皂-牛蒡當歸養生皂禮盒、南方廣告行銷策略企業舍-飛舞的智慧-琉璃工藝手鍊、雲裳縫紉手藝坊-客家風染布包、蜻蜓雅築-相挺相隨(伸縮鍊)、樂木生活工作室-檜樂好食組。
好店組:「春日。佐光」人文和風燒鍋、LiLi手作烘焙、Eske Place Coffee House、水月囍樓、牛園、咕嘰咕嘰早午餐民族店、祝媽媽早餐、張家食堂、福灣莊園巧克力有限公司、鄭媽媽手工牛軋糖。相關資訊可至屏東伴手禮暨好店徵選活動網查詢。
屏東十大伴手禮及好店出爐。(記者羅欣貞攝)
屏東十大伴手禮。(記者羅欣貞攝)【自由時報】屏東十大伴手禮暨好店出爐 今天頒獎more -

【中時新聞網】屏東好食!十大伴手禮出爐
16:232017/08/04
中時|中國、 林和生
屏東十大伴手禮徵選出爐,共選出食品組、非食品組及好店組商家30名店家。(林和生攝)
屏東十大伴手禮暨好店徵選,共選出30組店家成為屏東好食、好物及好店代言人。(林和生攝)
兩年一度的屏東十大伴手禮暨好店徵選,歷經2個多月評審及網路投票,吸引超過43萬人次參與,堪稱有史以來最踴躍的一次,最後評選出食品組、非食品組及好店組商家共30名,未來將透過屏東縣政府宣傳,成為屏東好食、好物及好店代言人。
今年屏東伴手禮暨好店徵選活動,共有來自屏東各地共109間店家、147件產品報名參賽,戰況激烈堪稱空前,屏縣府為求慎重,除邀請產業專家擔任評審外,並展開為期一個月網路票選活動,最後各組選出10名。
屏東縣長潘孟安今日特地出席頒獎典禮,還特地與30間得獎店家一同上台走秀,展示入選產品,他說,伴手禮徵選活動邁入第4屆,商品與店家豐富而多元,更可喜的是,除傳統老店外,還有年輕人展現創意,令人耳目一新。
潘孟安也強調,透過伴手禮暨好店活動發掘屏東優質店家,未來民眾除了到屏東旅遊購買伴手禮有更多選擇外,縣府後續也將舉辦展售會及與網路平台行銷,讓更多人看見屏東物產的美好。
得獎名單如下:(不分名次按筆畫順序)
食品組:
六堆釀興業有限公司(豆油伯)-純釀無添加雙美好食味
多麥綠烘焙美食-黃金沙其瑪
佳鮇鮮生物科技股份有限公司-88津烤蝦
味益食品-東港fun輕鬆禮盒(海苔芝麻鮪魚鬆)
屏榮實業股份有限公司-屏榮蒲燒鰻魚禮盒
峰漁股份有限公司-【菌沛好漁】禮盒組
萃檸檬商號-檸檬茶佐原片
臺灣菸酒股份有限公司屏東酒廠-台酒紅麴豬腳
臻藏-鮮奶酪
鮮而美食品工業有限公司-鮮而美水果乾禮盒。
非食品組:
七星檀香有限公司-星洲陳盤香
大花農場-玫瑰精露
本革工坊-包粽零錢包
玉印霞飛手作坊-昌黎硯小吊飾
羽沛生物科技有限公司-羽沛沐香-諾麗果系列植萃皂禮盒
幸福手作皂-牛蒡當歸養生皂禮盒
南方廣告行銷策略企業舍-飛舞的智慧-琉璃工藝手鍊
雲裳縫紉手藝坊-客家風染布包
蜻蜓雅築-相挺相隨(伸縮鍊)
樂木生活工作室-檜樂好食組。
好店組:
「春日。佐光」人文和風燒鍋
LiLi手作烘焙
Eske Place Coffee House
水月囍樓
牛園
咕嘰咕嘰早午餐民族店
祝媽媽早餐
張家食堂
福灣莊園巧克力有限公司
鄭媽媽手工牛軋糖
屏縣府觀光傳播處長黃建嘉指出,這次伴手禮入選者極富特色,涵括農產及族群文化,像食品組有不少產品都是選用有機、無毒原料製做,迎合現代人健康養生風潮;原鄉的琉璃珠、客家染布、石硯等,也經巧思變成優雅飾品。評審特地把產品價格納入考量,保證民眾選購伴手禮CP值超高。
【中時新聞網】屏東好食!十大伴手禮出爐more -

【今日新聞】屏東青農劉建伸開創養殖品牌進駐農科拚育種(2017)
峰漁股份有限公司14日於農科園區新址舉辦開幕茶會,縣長潘孟安親臨現場祝賀。(圖/記者陳宗傑攝,2017.07.14)
【今日新聞】
峰漁股份有限公司今(14)日上午於農科園區新址舉辦開幕茶會,縣長潘孟安親臨現場祝賀,並表示,傳統產業結合生物科技進駐農科,是農業大學第一屆學員成功的案例,也是青年創業的典範,研發的路途坎坷,峰漁仍屹立不搖,為農業生物科技邁向新的里程碑。
峰漁公司創辦人劉建伸表示,從無到有的創業之路並不容易,經過當養魚學徒、募資、租魚塭、設立養殖公司、開創品牌及推展銷售等經歷,雖當選105年度養殖組百大青農,但仍深感自己對水產養殖之不足,希望透過與各領域專家學者合作來提升自己在養殖上的經驗,並以技術轉移、產學合作、計畫提擬的方式來加速水產養殖短期目標的實現。
7年級生劉建伸與妻子王靜儀以循環水及餵養益生菌的獨特養殖方式養殖鱸魚並進行推廣。
劉建伸先生是屏東女婿,在長治鄉開創養殖品牌,以循環水及餵養益生菌的獨特養殖方式養殖鱸魚並進行推廣,致力實現友善環境與提供安心食材的理念。劉建伸的妻子王靜儀小姐則是屏東縣政府開辦的農業大學第1屆畢業學員,主修行銷財務管理並致力於產品推廣。夫妻倆也招募屏東在地7、8年級擁有共同理念之青年夥伴一起加入,品牌事業漸上軌道,並於106年正式進駐屏東縣農業生技園區。
峰漁公司目前使用益生菌添加於飼料中增加魚體品質,進而提升產品價值,並取得產銷履歷認證、積極投入永續養殖育種計畫,以保護種原及提供穩定種苗為中長期目標,也發揮年輕人的創意開發水草培養技術並製成文創商品,相當吸睛,有望成為下一個屏東青創之星。
會中還有暢銷名廚-蔡萬利主廚及洋食王子-楊勝凱主廚現場示範鱸魚創意料理秀。【今日新聞】屏東青農劉建伸開創養殖品牌進駐農科拚育種(2017)more -

【亞太新聞網】百大青農成功開創養殖品牌 峰漁進駐農科拚育種(2017)
【亞太新聞網/記者范家豪/長治報導】
由屏東百大青農所成功開創的峰漁股份有限公司,今14日上午於長治農科園區新址舉辦開幕茶會,縣長潘孟安、農科園區張主任及農糧署南區分署長姚志旺等人親臨現場揭牌並表達祝賀,會中還有暢銷名廚-蔡萬利及洋食王子-楊勝凱二位主廚於現場示範鱸魚創意料理秀,配上伯大尼之家的小朋友表演熱情打鼓秀,活動現場熱鬧非凡。
▲潘縣長、農科園區張主任及農糧署南區姚分署長等共同揭牌。(圖/記者范家豪)
潘縣長表示,傳統產業結合生物科技進駐農科,是農業大學第一屆學員成功的案例,也是青年創業的典範,研發的路途坎坷,峰漁仍屹立不搖,為農業生物科技邁向新的里程碑,且強調峰漁的劉老闆兩夫妻是在辦理熱博彩稻田時為他們證婚的。
峰漁公司創辦人劉建伸表示,本身並無水產養殖相關背景,家裡也不是事養殖業,純粹因為對水產養殖有著無比熱忱而投入養殖業,雖當選105年度養殖組百大青農,但仍深感自己對水產養殖之不足,希望透過與各領域專家學者合作來提升自己在養殖上的經驗,並以技術轉移、產學合作、計畫提擬的方式來加速水產養殖短期目標的實現。
▲峰漁公司創辦人劉建伸兩夫妻。(圖/記者范家豪)
「從無到有的創業之路並不容易」劉建伸指出,經過當養魚學徒、募資、租魚塭、設立養殖公司、開創品牌及推展銷售等經歷,目前也與屏東當地水產養殖合作社及產銷班合作聯盟,並且感謝屏東縣政府、行政院農業委員會水產試驗所及相關單位多方輔導協助。
劉建伸是屏東女婿,在長治鄉開創養殖品牌,以循環水及餵養益生菌的獨特養殖方式養殖鱸魚並進行推廣,致力實現友善環境與提供安心食材的理念。劉建伸的妻子王靜儀小姐則是屏東縣政府開辦的農業大學第1屆畢業學員,主修行銷財務管理並致力於產品推廣。
夫妻倆也招募屏東在地7、8年級擁有共同理念之青年夥伴一起加入,品牌事業漸上軌道,並於106年正式進駐屏東縣農業生技園區,希望在園區內除了持續提升水產品品質與創新商品外,更力拼水產養殖前端育種繁養殖研發,期望為台灣漁業養殖種原未來盡一份心力。
峰漁公司目前使用益生菌添加於飼料中增加魚體品質,進而提升產品價值並取得產銷履歷認證、並積極投入永續養殖育種計畫,以保護種原及提供穩定種苗為中長期目標,也發揮年輕人的創意開發水草培養技術並製成文創商品,相當吸睛,有望成為下一個屏東青創之星。
▲蔡萬利及楊勝凱二位主廚現場示範鱸魚創意料理秀。(圖/記者范家豪)
【亞太新聞網】百大青農成功開創養殖品牌 峰漁進駐農科拚育種(2017)more -

【今日新聞 in Yahoo】屏東青農劉建伸開創養殖品牌 進駐農科拚育種
記者陳宗傑/屏東報導
峰漁股份有限公司14日於農科園區新址舉辦開幕茶會,縣長潘孟安親臨現場祝賀。(圖/記者陳宗傑攝,2017.07.14)
峰漁股份有限公司今(14)日上午於農科園區新址舉辦開幕茶會,縣長潘孟安親臨現場祝賀,並表示,傳統產業結合生物科技進駐農科,是農業大學第一屆學員成功的案例,也是青年創業的典範,研發的路途坎坷,峰漁仍屹立不搖,為農業生物科技邁向新的里程碑。
峰漁公司創辦人劉建伸表示,從無到有的創業之路並不容易,經過當養魚學徒、募資、租魚塭、設立養殖公司、開創品牌及推展銷售等經歷,雖當選105年度養殖組百大青農,但仍深感自己對水產養殖之不足,希望透過與各領域專家學者合作來提升自己在養殖上的經驗,並以技術轉移、產學合作、計畫提擬的方式來加速水產養殖短期目標的實現。
7年級生劉建伸與妻子王靜儀以循環水及餵養益生菌的獨特養殖方式養殖鱸魚並進行推廣。(圖/記者陳宗傑攝,2017.07.14)
劉建伸先生是屏東女婿,在長治鄉開創養殖品牌,以循環水及餵養益生菌的獨特養殖方式養殖鱸魚並進行推廣,致力實現友善環境與提供安心食材的理念。劉建伸的妻子王靜儀小姐則是屏東縣政府開辦的農業大學第1屆畢業學員,主修行銷財務管理並致力於產品推廣。夫妻倆也招募屏東在地7、8年級擁有共同理念之青年夥伴一起加入,品牌事業漸上軌道,並於106年正式進駐屏東縣農業生技園區。
峰漁公司目前使用益生菌添加於飼料中增加魚體品質。(圖/記者陳宗傑攝,2017.07.14)
峰漁公司目前使用益生菌添加於飼料中增加魚體品質,進而提升產品價值,並取得產銷履歷認證、積極投入永續養殖育種計畫,以保護種原及提供穩定種苗為中長期目標,也發揮年輕人的創意開發水草培養技術並製成文創商品,相當吸睛,有望成為下一個屏東青創之星。
會中還有暢銷名廚-蔡萬利主廚及洋食王子-楊勝凱主廚現場示範鱸魚創意料理秀。(圖/記者陳宗傑攝,2017.07.14)
【今日新聞 in Yahoo】屏東青農劉建伸開創養殖品牌 進駐農科拚育種more